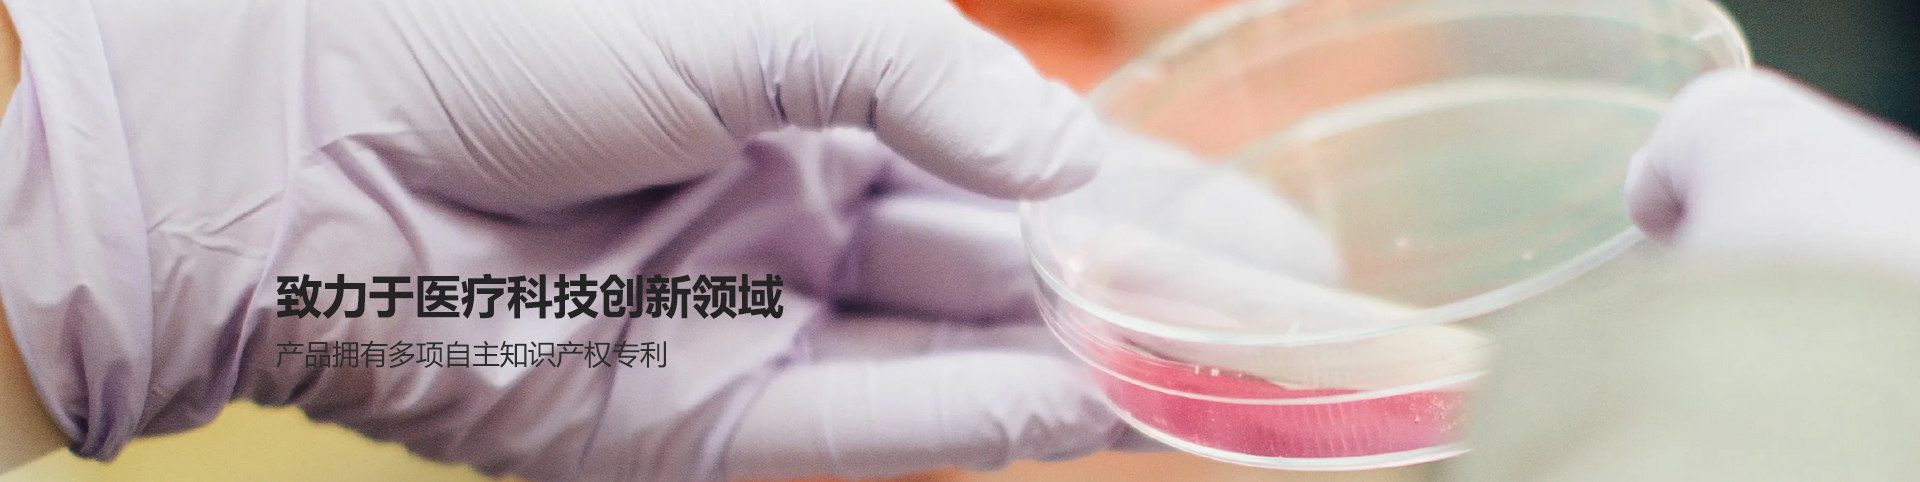
百万文字论文500308-500505百万文字论坛字论文查询-500505百万文字论坛最新版本-03024百万文字综合论坛-百万综合文字论文798790-500507百万文字论坛综合-500507百万文字论文网站简介

百万文字论文500308-500505百万文字论坛字论文查询-500505百万文字论坛最新版本-03024百万文字综合论坛-百万综合文字论文798790-500507百万文字论坛综合-500507百万文字论文网站前身为金华市无线电厂(金华市电子医疗仪器厂),1997年改制组建,公司注册资金302万元,是一家集科、工、贸一体的医疗器械高科技实体。2007年被认定为金华市工业设计创新示范企业;2009年被认定为浙江省优秀民营企业,2010年被认定为金华市高新技术企业;2011年被认定为金华市专利示范企业;2012年认定为金华市创新型企业;2013年由金华市科技局认定为高新技术研究开发中心;2014年由华夏认证中心通过信息安全管理体系认证;2015年由中国制造网通过认证为指定制造供应商。
公司近三十年生产全套生物病理组织学产品的经验,先后承担了省、市重点科研项目多项,研发了多种半自动、全自动超薄生物组织切片机,多款式全自动生物组织脱水机,全自动生物组织包埋机,生物组织摊烤片机、生物组织染色机等等。
2010-2013年间公司自行设计制造了首台套病理一次性刀片的成套流水线设备,年产量可达三千万片病理一次性刀片提供给市场。公司对产品拥有自主知识产权,已授权多项发明专利,新型实用专利、多项外砚专利。每年都有高科技的新产品出台。公司以不断的创新和开发新的产品为目标,争取提供更好更优的产品为市场服务。
公司产品在全国各级医院、生物医学、生命科学、农林、教育、卫生防疫、畜牧兽医、公安法医、科研机构、实验室等部门广泛使用,凭借稳定的质量和良好的售后服务,取得用户的一致好评。特别在农业部“畜牧业无规定疫病区建设”、“动物疫情监测”等项目中连续中标、采购。出口远销欧洲、美洲、中东、非洲、东南亚等国际市场。公司宗旨:顾客满意、诚信服务、科技创新、合理价格来服务回报广大的客户。

改制组建
注册资金
出口远销国家地区
信用等级








 浙江省金华市工业园区秋滨街道始丰路899号
浙江省金华市工业园区秋滨街道始丰路899号  jhkedi@zjkedi.com 销售热线: 0579-82338734/83522561/83522099
jhkedi@zjkedi.com 销售热线: 0579-82338734/83522561/83522099 

 浙公网安备33071802100574号
浙公网安备33071802100574号